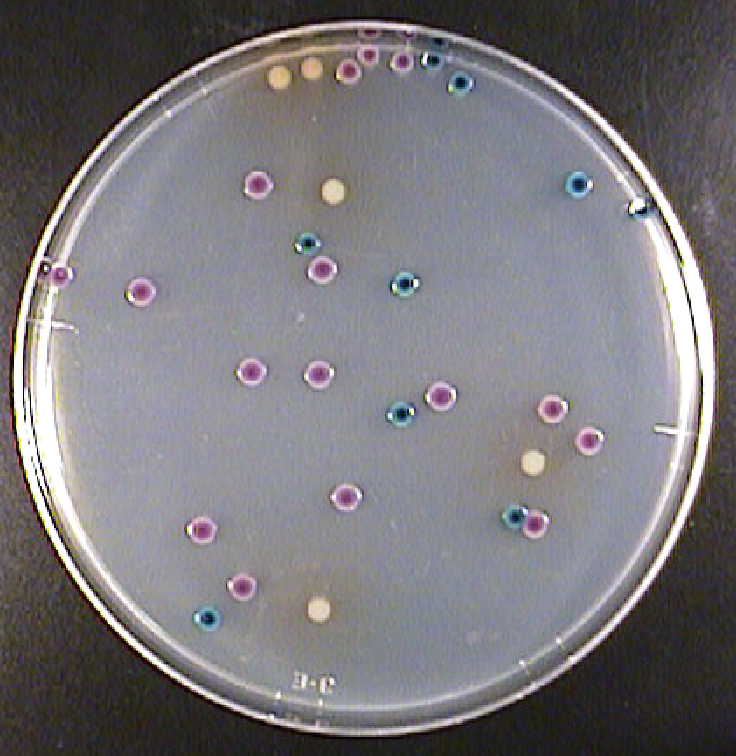

特集・大腸菌・大腸菌群の制御法:技術FOCUS1=エルメックス
◇(株)エルメックス 「Pro・media ST-SSP/アガートリコロール」
簡便・迅速に大腸菌群と大腸菌を同時に検査できる酵素基質培地
*
微生物検査の分野でも、人手不足対策や業務効率化などを背景に、業務の簡便化や迅速化、自動化のニーズが高まっている。そうしたニーズに対応した培地やスワブ、コロニーカウンター、関連資材などを次々と開発・上市しているエルメックスは、大腸菌群と大腸菌を同時に検査できる酵素基